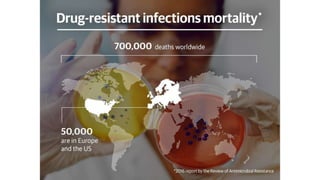
⚫Nearly 700,000 people around
the world die every year due to
drug- resistant infections.

Antimicrobial resistance is a serious global public health threat that causes nearly 700,000 deaths per year. Bacteria develop resistance through natural and acquired mechanisms such as modifying drug targets, inactivating drugs, or pumping drugs out of cells. Resistance is increasing due to overuse and misuse of antibiotics in medicine, agriculture, and consumer products. Effective solutions require coordinated efforts across all sectors to slow the development of antimicrobial resistance.

![⚫Bacteria possess chromosomally encoded genes for efflux
pumps. Some are expressed constitutively, and others are
induced or overexpressed (high-level resistance is usually via
a mutation that modifies the transport channel) under certain
environmental stimuli or when a suitable substrate is present.
⚫The efflux pumps function primarily to rid the bacterial cell of
toxic substances, and many of these pumps will transport a
large variety of compounds (multi-drug [MDR] efflux pumps).
4. Active efflux of a drug.](https://image.slidesharecdn.com/antibiotcresistance-191028163013-221119084711-b8a10c06/85/antibiotcresistance-191028163013-pptx-37-320.jpg)






